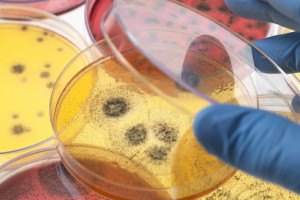

Dienstag, 14. April 2020
Am Wochenende bin ich punkto Recycling eine Extrameile gegangen. Mit dem Sohn zusammen habe ich einen ausgedienten Rasenmähroboter komplett auseinander genommen und alle Materialien getrennt. Tatsächlich könnten wir Metalle von Plastik (Alle grösseren Teile haben zumindest ein Recyclinglogo) komplett trennen. Übrig bleiben viele Kabel und die Elektronik. Sogar den Akku konnten wir komplett zerlegen um die Zellen separat zu recyclen. Einen der drei Elektromotoren und einen Supermagneten behalten wir für ein kleines Raspberry Pi Experiment. Heute fahre ich im Nachbardorf zum Wertstoffhof, wo ich alles separat abgeben kann. Selbst für die verschiedenen Schrauben hat es dort kleine Behälter. Ich bin gespannt wie man dort auf den zerlegten Roboter reagiert.
Elektromobilität
Wie teuer es wirklich ist, ein Elektroauto zu fahren
Hoher Kaufpreis, günstiger Unterhalt- aber was kommt dabei unterm Strich heraus? Was kostet ein E-Auto Monat für Monat im Vergleich mit einem Benziner oder Diesel? Die Bilanz bei den kleinesten Modellen ist, inkl. der Prämien in DE, ziemlich gut.
Kriterien bei der Wahl eines E-Autos
Die Elektromobilität ist auch in der Schweiz auf dem Vormarsch, immer mehr Hersteller bringen elektrisch betriebene Modelle auf den Markt. Wer ein E-Auto kaufen will, sollte vor dem Entscheid mindestens drei Kriterien berücksichtigen: Umweltbelastung, Kosten und Ladeinfrastruktur.
Zulassungsrekord für Elektroautos im März 2020
Die Auswirkungen des Corona-Shutdowns haben die März-Zulassungen noch verschont, sodass es noch einmal für einen Rekord gereicht hat. Erstmals wurde die magische Grenze von 10'000 neuzugelassenen Elektroautos in einem Monat durchbrochen, das entspricht fast 5% aller Zulassungen in Deutschland.
VW steigt ins Geschäft mit Schnellladern ein
Wohin mit den Alt-Batterien der Elektroautos? Volkswagen findet: Am besten sind sie in mobilen, flexibel nutzbaren Ladestationen aufgehoben. In Wolfsburg stehen bereits ein Dutzend Säulen des neuen Typs.
Schweiz
ewz baut erste hochalpine Solar-Grossanlage
Der Zuschlag kam zwar nach der Axpo, aber wenn alles gut geht, steht diese Anlage bereits ein Jahr vorher: Mit den über 1200 PV-Modulen mit einer Gesamtleistung von 410 kWp können pro Jahr rund 500 mWh Sonnenstrom produziert werden.
Appenzell Ausserrhoden unterstützt Ersatz fossiler Heizungen
Schonen die Umwelt und allenfalls auch das Portemonnaie: erneuerbare Energien. Eine Beratung zum Thema soll Unklarheiten beseitigen und helfen, den idealen Ersatz zum fossilen Heizungssystem zu finden. Gewisse Massnahmen können dann auch von den Steuern abgezogen werden.
Widerstand gegen Swiss-Rettungspaket wächst
Bedenken gibt es viele: Immerhin musste die damalige Swissair im 2001 schon einmal mit Bundesmilliarden gerettet werden. Nun stehen Flugzeuge der heutigen Swiss wieder still. Die Airline-Branche leidet besonders unter der Corona-Krise. Erneut prüft der Bundesrat daher Staatshilfe für die Schweizer Luftfahrt. Erneut geht es um Milliarden.
Edisun Power: Rekordergebnis und wichtige Weichenstellung
Mit dem Kauf einer Pipeline von 206 MW an Photovoltaikprojekten und der erfolgreichen Durchführung einer Kapitalerhöhung von über CHF 50 Millionen hat Edisun Power 2019 wichtige Weichen für die Zukunft gestellt. Aus finanzieller Sicht konnte das Berichtsjahr ebenfalls sehr positiv abgeschlossen werden. Primär dank erstmaligen Erträgen aus dem Projektentwicklungsgeschäft resultierte trotz tieferen Strompreisen erneut ein Rekordgewinn von CHF 3.60 Mio.
Klimawandel
Methan, das Gas, das kaum jemand sucht
Das Klimagas Methan ist 20- bis 30-mal klimawirksamer als Kohlendioxid, aber relativ kurzlebig. Nach 20 Jahren ist es weitgehend verschwunden. Methanemissionen zu reduzieren wäre ein gutes Mittel, um die Erderwärmung schnell zu bremsen. Etwa 35% der Emissionen entstehen bei der Förderung von Erdöl und dem Abbau von Kohle.
Corona-Krise zeigt wie fossile Energien die Luft verschmutzen
Zum Weltgesundheitstag wies die IG Windkraft darauf hin, dass mit erneuerbaren Energien viele Menschenleben gerettet werden könnten. Allein in Europa sterben pro Jahr rund 400.000 Menschen aufgrund der Verbrennung von Erdgas, Erdöl und Kohle, wie eine aktuelle Studie berichtet.
Wissen(schaft)
Professor Ego
Hierfür lohnt sich das Probeabo: Günther Schuh wollte E-Autos für jedermann bauen und forderte damit die grossen Autokonzerne heraus. Doch nun muss sein Start-up E.Go ums Überleben kämpfen. Von einem, der glaubte, alles besser zu wissen.
Mikroben fernab von Coronaviren: Klimaschützer Bakterien
Mikroben haben es zurzeit nicht leicht. Da kommt diese Meldung gerade recht: In der Arktis fressen Bakterien offenbar klimaschädliches Methan. Das könnte eine der gefährlichsten "Klimabomben" des Planeten entschärfen helfen.
Langfristig weniger Flugverkehr: Das Ende der Superkonjunktur
Die Lufthansa verkleinert ihre Flotte, Boeing und Airbus legen zeitweise die Produktion still. Corona und die Klimakrise werfen den Flugverkehr möglicherweise auf Jahre zurück. Der grösste Konkurrent in Europa ist der Zug.
Europa
Plastikmüll: Verändertes Enzym recycelt Kunststoff
Tüten, Flaschen, Verpackungen: Plastik ist überall, die Entsorgung ist jedoch schwierig. Bei mechanischem Recycling nimmt die Qualität des Kunststoffs ab. Chemisches Recycling ist noch nicht sehr verbreitet. Das französische Unternehmen Carbios hat möglicherweise eine Lösung für das Problem gefunden: ein Enzym, das Plastik zersetzt.
Bewusster leben
Sojahack zu Ostern?
Die Lage ist sehr eindeutig. Mit Ausnahme von Laborfleisch schneiden alle Fleischalternativen bei der Umwelt- und Klimabelastung besser ab als herkömmliches Fleisch. Darin seien sich die von ihm überprüften Studien einig, so Umweltwissenschaftler Antony.